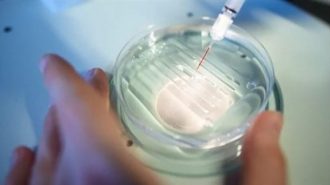

- اخر الاخبار
- امن
-
تابعنا على Facebook
RSS FEED الملقم الاخباري
-
أنتقل الى
تواصل معنا
صحة و جمال
للرجال والصحة الجنسية.. 10 فوائد مذهلة للطماطم
تعتبر الطماطم من أشهى أنواع الخضراوات حول العالم وأكثرها استهلاكاً، وتستخدم في إعداد أغلب أنواع الأطعمة. وعلى اختلاف أنواعها، تحتوي الطماطم على عناصر غذائية مهمة جداً للصحة كالفيتامينات والمعادن ومضادات الأكسدة. ومن فوائد الطماطم للرجال: تحسين نوعية وقدرة الحيوانات المنوية على الحركة. يقي الحيوانات المنوية من الالتهابات والتشوهات. يزيد من سرعة وجودة الحيوانات المنوية. تسهيل المزيد
فوائد بالجملة للمشي حافي القدمين والسبب
كشف اطباء روس، عن فائدة صحية كبيرة من سير الإنسان حافيا دون حذاء. وأوضح الطبيب الروسي فلاديمير خوروشيف: “المشي حافيا يحفز وينشط جميع أعضاء وأنظمة الجسم عن طريق تدليك المزيد
فيتامينات هامة يجب الحصول عليها في الصيف
يرافق فصل الصيف مجموعة من المشكلات الصحية الناتجة عن ارتفاع درجات الحرارة وانتشار الأمراض المعدية، لذلك من المهم تعزيز صحة الجسم وتقوية مناعته. وهو ما يتعين علينا الحصول على المزيد
المكمل الغذائي رقم 1 لرفع طاقة الجسم ليس فيتامين C
يكافح الكثيرون من أجل رفع كفاءة الأداء خلال تنفيذ الأعمال اليومية، حيث نشعر في أغلب الأحيان بالنعاس أو التعب في فترات الظهيرة أو بعد تناول وجبة الطعام في العمل. المزيد
أغذية مفيدة للكبد
تعتمد وظيفة الكبد على النظام الغذائي اليومي. عدد الخبراء المنتجات التي تفيد الكبد. تشمل القائمة الشاي الأخضر والخضروات الصليبية والكركم. وتشمل أيضًا ثمار الحمضيات، والتي تعد المصدر الرئيسي لفيتامين المزيد
5 أطعمة تساعد في تحسين صحتك
قام الأطباء بإدراج خمسة أطعمة تساعد في تحسين صحة الشخص. يعتقد الخبراء أنه في الصيف، من الضروري إيلاء اهتمام خاص للتوت البري والفواكه، لأنها تحتوي على تركيبة غنية بالفيتامينات. المزيد
تقنية جديدة لتعديل الجينات
يَعِدُ تعديل الجينات بتقنية كريسبر بمكافحة الأمراض التي كان يُعتقد في السابق أنها غير قابلة للشفاء، لكن التقنية لا تزال تتطلب حقن المواد مباشرة في الخلايا المصابة، وهذا يجعلها المزيد
زجاجات المياه البلاستيكية تقلل معدل الخصوبة
يؤدي استخدام زجاجات المياه البلاستيكية لأكثر من مرة إلى أمراض خطيرة، بما في ذلك تقليل معدل الخصوبة. وحذر تقرير نشره موقع express من أن إعادة استخدام تلك الزجاجات قد المزيد
أفضل أفكار الإفطار لزيادة الطاقة وخفض السكر في الدم
يؤدي السكري النوع 2 إلى ظهور أعراض مثل التعب أو عدم وضوح الرؤية أو كثرة التبول. وعندما ترتفع نسبة السكر في الدم، يمكن أن تصبح الأعراض أسوأ. فما هي المزيد
فوائد غسول الفم: مهمة وعديدة
لا تقتصر فوائد غسول الفم فقط على تطهير فمك وإعطائه رائحة منعشة والتخلص من البكتيريا وفطريات اللسان والأسنان. في الحقيقة يحمل غسول الفم العديد من الفوائد الأخرى التي يجهلها المزيد